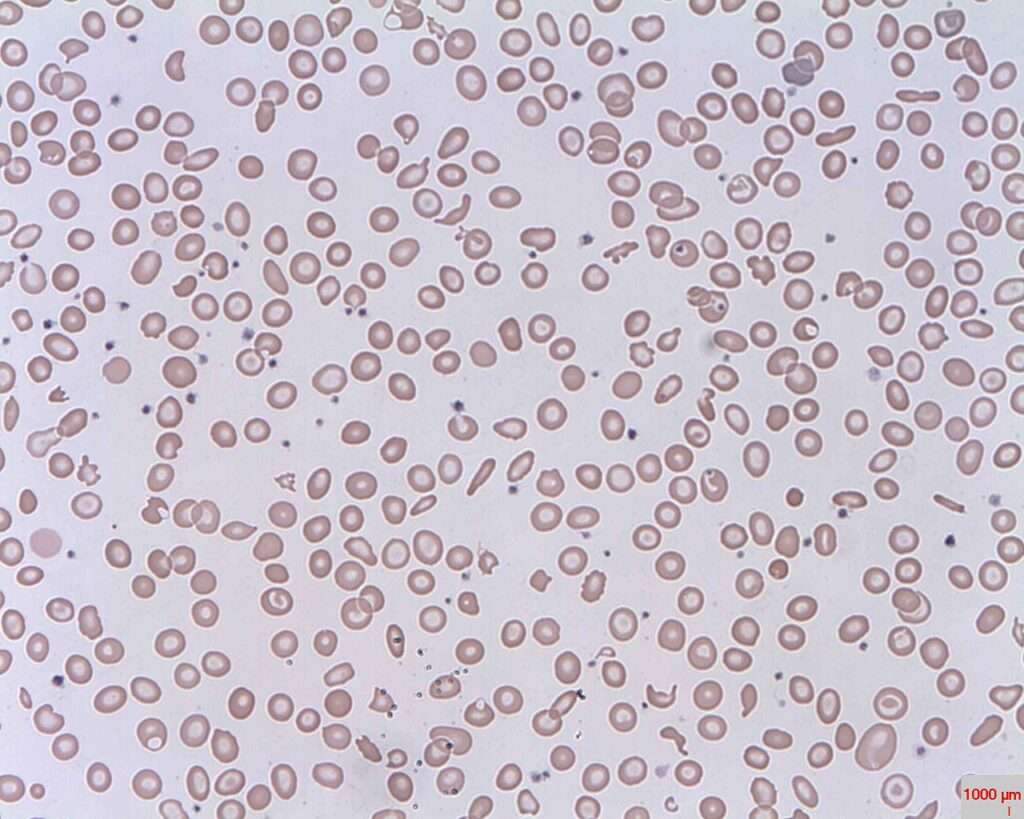
Clasificación de las anemias hemolíticas

Las anemias hemolíticas son un grupo de trastornos en los cuales la supervivencia de los glóbulos rojos está reducida, ya sea de forma episódica o continua. El cuerpo tiene la capacidad de aumentar la producción eritroide en la médula ósea hasta ocho veces en respuesta a una disminución de la supervivencia de los glóbulos rojos, por lo que la anemia solo será evidente cuando la capacidad de compensación de la médula ósea se vea superada. Esto ocurre cuando la supervivencia de los glóbulos rojos es extremadamente corta o cuando la capacidad de la médula ósea para compensar la pérdida celular se ve comprometida.
Los trastornos hemolíticos generalmente se clasifican en función de si el defecto es intrínseco al glóbulo rojo o si es causado por factores externos. Los defectos intrínsecos se han descrito en todos los componentes del glóbulo rojo, incluidos la membrana, los sistemas enzimáticos y la hemoglobina, y la mayoría de estos trastornos son hereditarios. Las anemias hemolíticas debidas a factores externos se clasifican como inmunológicas, microangiopáticas, inducidas por fármacos, por infección de los glóbulos rojos o relacionadas con quemaduras.
La clasificación de las anemias hemolíticas ayuda a orientar el diagnóstico y tratamiento, ya que los enfoques terapéuticos varían según el tipo de defecto que cause la destrucción prematura de los glóbulos rojos.
La clasificación de las anemias hemolíticas se puede dividir en dos grandes categorías: extrínsecas e intrínsecas, dependiendo de si el defecto que provoca la destrucción de los glóbulos rojos es debido a factores externos al glóbulo rojo o a defectos inherentes a su estructura o función. A continuación se presenta una lista detallada de las causas dentro de cada categoría, ordenada alfabéticamente dentro de cada subgrupo.
Anemias hemolíticas extrínsecas
Las anemias hemolíticas extrínsecas son causadas por factores externos al glóbulo rojo, como trastornos inmunológicos, infecciones, o condiciones que afectan la circulación o el entorno en el que los glóbulos rojos circulan.
- Quemaduras
Las quemaduras graves pueden causar daño directo a los glóbulos rojos, contribuyendo a su destrucción acelerada. - Hipersplenismo
El aumento de la actividad del bazo puede llevar a la destrucción excesiva de glóbulos rojos. Esto puede ocurrir en diversas condiciones, como enfermedades hepáticas o mieloproliferativas. - Inmunológicas
- Autoinmunes: Las anemias hemolíticas autoinmunes son causadas por la producción de anticuerpos contra los glóbulos rojos del propio cuerpo.
- Enfermedades linfoproliferativas: Trastornos como linfoma o leucemia pueden inducir la destrucción de glóbulos rojos.
- Inducidas por fármacos: Algunos fármacos pueden inducir la producción de anticuerpos que atacan los glóbulos rojos.
- Idiopáticas: En algunos casos, la causa subyacente de la hemólisis autoinmune no puede ser identificada.
- Infección
- Plasmodium: El parásito causante de la malaria puede destruir glóbulos rojos.
- Clostridium: Algunas infecciones por Clostridium, como la gangrena gaseosa, pueden causar hemólisis.
- Borrelia: La bacteria responsable de la enfermedad de Lyme puede inducir hemólisis en algunos casos.
- Microangiopáticas
- Púrpura trombocitopénica trombótica (PTT): Es una enfermedad caracterizada por la formación de microtrombos que dañan los glóbulos rojos.
- Síndrome hemolítico-urémico (SHU): Similar a la PTT, causa daño a los glóbulos rojos debido a la formación de trombos en pequeños vasos sanguíneos.
- Coagulación intravascular diseminada (CID): Es una condición caracterizada por la formación masiva de coágulos en los vasos pequeños, que destruyen los glóbulos rojos.
- Hemólisis por válvula: Las prótesis valvulares pueden causar daño mecánico a los glóbulos rojos.
- Embarazo: En algunas mujeres embarazadas, especialmente en el contexto de hipertensión o preeclampsia, puede haber hemólisis microangiopática.
- Familiares: Algunas formas hereditarias de hemólisis microangiopática existen, como la trombocitopatía hereditaria.
- Cáncer metastásico: El adenocarcinoma metastásico, especialmente el adenocarcinoma de páncreas o pulmón, puede causar microangiopatía.
- Vasculitis: La inflamación de los vasos sanguíneos puede dañar los glóbulos rojos.
- Sobrecarga de cobre: La acumulación de cobre en el cuerpo puede inducir daño a los glóbulos rojos.
Anemias hemolíticas intrínsecas
Las anemias hemolíticas intrínsecas son causadas por defectos en los propios glóbulos rojos, lo que provoca su destrucción prematura.
- Defectos glicolíticos
- Deficiencia de piruvato quinasa: Este defecto enzimático impide la conversión adecuada de la glucosa, afectando la integridad de los glóbulos rojos.
- Hipofosfatemia severa: Niveles bajos de fosfato pueden afectar la función metabólica de los glóbulos rojos, llevando a su destrucción.
- Hemoglobinopatías
- Síndromes de células falciformes: La hemoglobina S causa la deformación de los glóbulos rojos, lo que los lleva a destruirse más rápidamente.
- Talasemia: Un defecto en la producción de hemoglobina, que lleva a la destrucción prematura de los glóbulos rojos.
- Hemoglobinas inestables: Algunas formas anormales de hemoglobina pueden ser inestables, lo que conduce a la hemólisis.
- Defectos de membrana
- Esferocitosis hereditaria: Los glóbulos rojos tienen una forma esférica anormal, lo que los hace más propensos a la destrucción.
- Eliptocitosis hereditaria: Similar a la esferocitosis, pero los glóbulos rojos tienen una forma elíptica anormal.
- Hemoglobinuria nocturna paroxística: Un trastorno raro que causa la destrucción de los glóbulos rojos durante la noche.
- Vulnerabilidad a la oxidación
- Deficiencia de glucosa-6-fosfato deshidrogenasa: La deficiencia de esta enzima hace que los glóbulos rojos sean más susceptibles al daño oxidativo.
- Metahemoglobinemia: En esta condición, los glóbulos rojos tienen una forma de hemoglobina alterada que no puede transportar oxígeno de manera efectiva, lo que lleva a su destrucción.
En todas las anemias hemolíticas existen características de laboratorio comunes que son útiles para el diagnóstico y la evaluación de la severidad del trastorno. Uno de los indicadores clave es la haptoglobina, una proteína plasmática normal cuya función principal es unirse a la hemoglobina libre liberada en el plasma durante la destrucción de los glóbulos rojos, y facilitar su eliminación. En las anemias hemolíticas, los niveles de haptoglobina suelen estar disminuidos debido a que se consume en el proceso de unión con la hemoglobina liberada. Sin embargo, la haptoglobina no siempre es un marcador fiable de hemólisis, ya que su concentración puede verse influenciada por diversos factores, como enfermedades hepáticas avanzadas. Esto se debe a que la haptoglobina es producida en el hígado, y en enfermedades hepáticas terminales, la capacidad del hígado para sintetizarla puede estar comprometida, lo que dificulta su uso como indicador preciso de hemólisis.
Cuando ocurre hemólisis intravascular (destrucción de glóbulos rojos dentro de los vasos sanguíneos), se produce una condición transitoria conocida como hemoglobinemia (presencia de hemoglobina libre en el plasma). La hemoglobina liberada en el plasma es filtrada a través del glomérulo renal y, en condiciones normales, es reabsorbida por las células tubulares del riñón. Sin embargo, si la cantidad de hemoglobina liberada excede la capacidad de reabsorción de los túbulos renales, se desarrollará hemoglobinuria, que se caracteriza por la presencia de hemoglobina en la orina. Es importante señalar que la hemoglobina en la orina solo será evidente cuando la carga de hemoglobina sobrepasada sea tal que los túbulos renales no puedan procesarla adecuadamente.
En ausencia de hemoglobinuria, la evidencia de hemólisis intravascular previa se puede detectar mediante la presencia de hemosiderina en las células renales tubulares exfoliadas, lo que se puede identificar mediante la prueba de hemosiderina en la orina. La hemosiderina es un depósito de hierro que se forma cuando el cuerpo intenta almacenar el hierro liberado durante la destrucción de la hemoglobina. Esta condición es indicativa de que ha habido un proceso de hemólisis importante y prolongado.
En los casos graves de hemólisis intravascular, además de la hemoglobinemia, puede observarse methemalbuminemia, que es la presencia de hemoglobina unida a albúmina en el plasma. Este hallazgo también es un signo de hemólisis significativa y contribuye a la evaluación de la magnitud del daño.
Otro marcador importante en las anemias hemolíticas es la bilirrubina indirecta, que se incrementa debido a la mayor degradación de la hemoglobina liberada por los glóbulos rojos destruidos. Este aumento de la bilirrubina indirecta puede ser un indicador de hemólisis activa. En algunos casos, la bilirrubina total puede superar los 4 mg/dL (68 micromoles por litro) o más, lo que indica un proceso hemolítico significativo. Sin embargo, niveles de bilirrubina más altos pueden también sugerir la presencia de alguna disfunción hepática, lo que sugiere que el hígado está comprometido en su capacidad para procesar la bilirrubina, lo que podría estar relacionado con condiciones patológicas concurrentes.
Por último, los niveles de lactato deshidrogenasa (LD) se elevan significativamente en ciertos tipos de hemólisis, especialmente en las hemólisis microangiopáticas (como en la púrpura trombocitopénica trombótica, el síndrome hemolítico-urémico y la coagulación intravascular diseminada), donde se produce daño a los glóbulos rojos debido a la formación de microtrombos en los vasos sanguíneos pequeños. En estos casos, la LD puede ser extremadamente alta, lo que refleja la destrucción celular tanto de los glóbulos rojos como de otras células involucradas en el proceso patológico. En otras formas de hemólisis, los niveles de LD pueden estar elevados, pero no tan marcadamente como en los trastornos microangiopáticos.

Fuente y lecturas recomendadas:
- Goldman, L., & Schafer, A. I. (Eds.). (2020). Goldman-Cecil Medicine (26th ed.). Elsevier.
- Loscalzo, J., Fauci, A. S., Kasper, D. L., Hauser, S. L., Longo, D. L., & Jameson, J. L. (Eds.). (2022). Harrison. Principios de medicina interna (21.ª ed.). McGraw-Hill Education.
- Papadakis, M. A., McPhee, S. J., Rabow, M. W., & McQuaid, K. R. (Eds.). (2024). Diagnóstico clínico y tratamiento 2025. McGraw Hill.